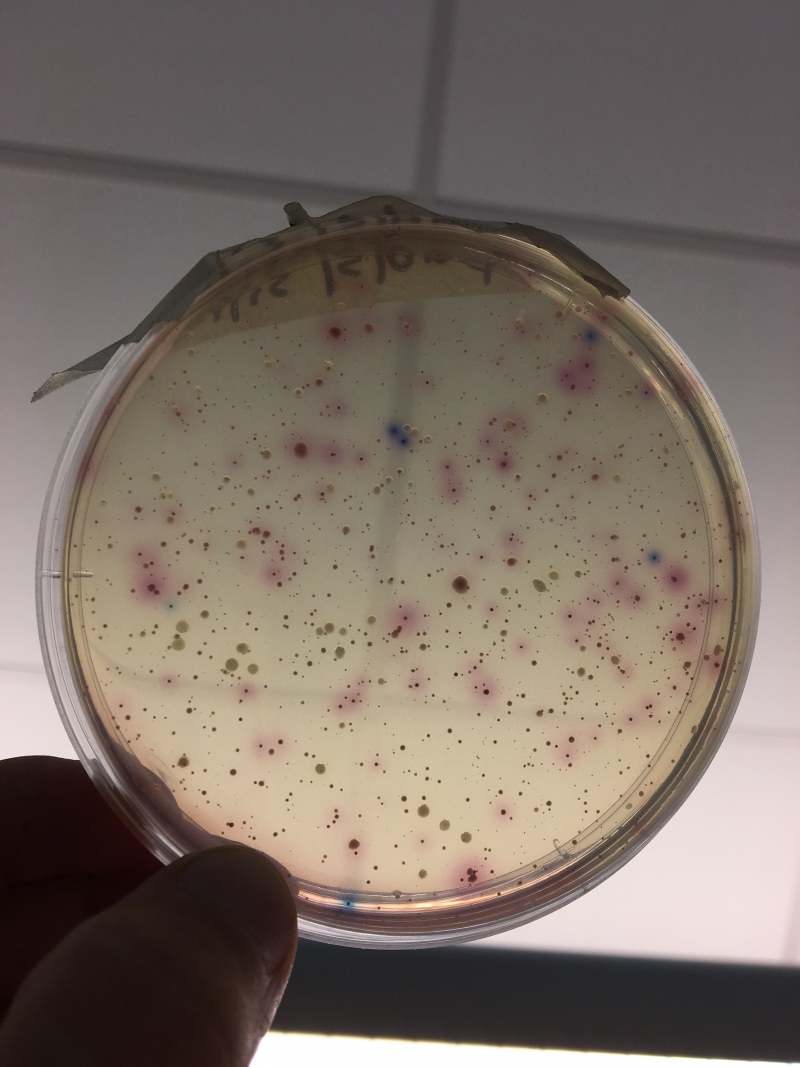

North Country explorer from Woodstock, Vermont
Last Monday I was at Heritage Park preparing for a water monitor training I was leading for Nature Up North. I aseptically collected a bottle of river water and brought it back to the biology lab at St. Lawrence University to grow the bacteria in the water sample on a petri plate. After two days of incubation this is what I got! These little colonies of E. coli and coliform bacteria grew and I counted them for our records. At first you might think "Ew! That bacteria grows in the river where I swim!" But these bacteria can help us to evaluate the health of the Grasse River and they are not all bad. We encounter these little beings all the time without noticing them, but they are a big part of a thriving river ecosystem that we all enjoy.
E. coli and Coliform bacteria colonies
